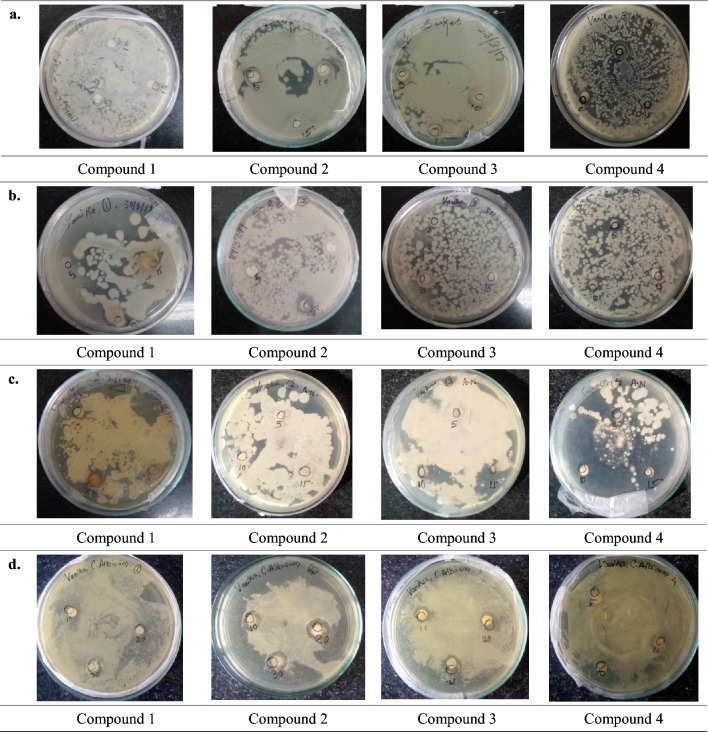
Fig. 2

Abstract
Antimicrobial Resistance (AMR) due to non-responding viruses, fungi, bacteria and parasites leads to discovery of new antimicrobial medicines which can control the risk of disease spread, severe illness, disability and death. Heterocyclic chemistry has always been a continuous supplier of novel antimicrobial agents which are in great demand in pharma sector. Therefore, compounds such as 1-(Chloromethyl)-1H-Benzotriazole, 1; 1-((1-H-benzo[d][1,2,3]triazol-1-yl)methyl)phenyl hydrazine, 2; 1-((1-H-benzo[d][1,2,3]triazol-1-yl)methyl)hydrazine, 3; and N-(benzo[e][1,2,4]triazin-4(3-H)-ylmethylbenzenamine, 4 were designed, and synthesized through conventional and microwave-assisted methods. All of these novel benzotriazoles were explored through in-vitro antimicrobial studies and in silico studies. Antimicrobial activity was carried out against bacterial strains Escherichia coli, Bacillus subtilis, and fungal strains Aspergillus niger and Candida albicans at concentrations 5, 10 and 15 mg/ml. In silico studies was carried out with 4CAW: Aspergillus fumigatus N-myristoyl transferase in complex with myristoyl CoA and a pyrazole sulphonamide ligand. Our antimicrobial and molecular docking studies revealed that all of the derivatives showed promising activity, moreover molecular docking gave significant values of ligand posed energy and docking run elapsed time which further endorsed the astonishing characteristic of benzotriazole derivatives esp. N-(benzo[e]a[1,2,4] triazin-4(3-H)-ylmethylbenzenamine for biological and therapeutic leads.
Keywords: Benzotriazole, Antimicrobial, Microwave, Computational, In-Silico
Introduction
Microbes are the prominent cause of infectious and non-infectious diseases all over the word. The virus, bacteria, fungus, protozoa etc. are so tiny to be seen through naked eyes but their impact on human, animal and plants cannot be ignored in pathological, biological and pharmacological context. Furthermore, Antimicrobial Resistance (AMR) is a global problem which affect the health system and national economies overall [1]; however, this is not the scope of our work but paves the way for the discovery of new derivatives. Several heterocyclic moieties have been studied for the antimicrobial actions till date, the significant number of derivatives of these moieties are selected as candidate, lead compounds and finally drugs for the treatment of microbial diseases. In order to that we selected benzotriazole moiety for antimicrobial studies. Benzotriazole is one of the potent moieties [2] which incorporated number of prominent properties like Photovoltaic cell, anticorrosive effect on copper and brass, toxicity and impact of benzotriazoles in the nature, in-vitro antifungal activity against Trichophyton rubrum, Epidermophyton floccosum, antifungal property against Trichophyton mentagrophyte, E. floccosum, T. rubrum, Microsporum canis and Candida albicans, anticancer activity, restricting the activity of CK2 (Caesin Kinase) in treating cancer [3–10]. In addition to that, Bosque et. al. showed a different strategy to cure HIV by using the activity of benzotriazole in reactivating latent HIV-1 [11]. Hongru et al. reported estrogenic activity of benzotriazole through in vitro assays and computational studies [12]. Sudhir et al. reported N-alkylated derivatives of benzotriazole for anthelmintic activity [13]. The acridine derivatives of benzotriazole were having potent antibacterial activity against Pseudomonas aeruginosa, Proteus vulgaris, Bacillus subtilis, Escherichia coli, Salmonella typhi, Klebsilla pneumoniae, Staphylococcus aureus, taken as clinical specimens [14]. Kumar et al. reported benzotriazole derivatives for the antibacterial activity against K. pneumoniae, P. aeruginosa, P. vulgaris, S. aureus, B. subtilis, E. coli, S. typhi. Antifungal activity was shown against C. albicans [15]. Suma et al. screened the derivatives having activity against gram-negative bacteria like E. coli, Proteus valgaris and gram-positive bacteria like S. aureus, B. subtilis, and observed antibacterial property [16]. Caliendo et al. reported the pharmacological activity of benzotriazole derivatives as local anaesthetic [17]. Benzotriazole derivatives of N-phenyl acetamide and carbamic acid were found showing antioxidative activity [18]. Jain et al. investigated the anti-inflammatory action of N-(Alkyl or Aryl)-2-(1H-benzotriazol-1-yl) acetamide derivatives of benzotriazole [19]. Furthermore, benzotriazole has been a subject of in-silico studies since couple of decades. Molecular docking has emerged as an effective tool in research and development in chemical sciences just like artificial intelligence, internet of things does in computer and electronic sciences [20]. In-silico studies reduces the time span of this selection to some extent with greater accuracy.
We thought to design and synthesize benzotriazoles which could prove its capacities through antimicrobial and computational studies. In present work, the benzotriazole derivatives (1–4) as per Fig. 1, were synthesized and studied for antimicrobial activity. This work was further given an extension through in-silico studies with protein 4CAW: Aspergillus fumigatus N-myristoyl transferase in complex with myristoyl CoA and a pyrazole sulphonamide ligand by analysing ligand pose energy and docking run elapsed time. These derivatives have not been screened against bacterial strains E. coli and B. subtilis and antifungal strains Aspergillus niger and C. albicans, moreover computational study of these derivatives with 4CAW is novel approach.
Fig. 1.

Benzotriazole derivatives (1–4). R1 = –Cl, –NHC6H4CH3, –NHNH2, –NHNHC6H5
Materials and Methods
The purity of the synthesized derivatives (1–4) was checked using TLC plates (glass) coated with silica gel. Melting points of the derivatives was determined by open capillary method. The developed chromatographic plates were visualized under iodine chamber. IR spectra were recorded using KBr on Shimadzu FTIR model 8400 spectrophotometer, and 1H NMR from Bruker Avance II 400 NMR spectrometer. Raga 700-W microwave oven was used for the synthesis. Antimicrobial activity was carried out by Disc diffusion method [21]. In silico studies was carried out through molecular docking using ArgusLab 4.0.1 software. The selected 4CAW protein is taken from RSCB protein data bank.
Experimental
General Procedure for Synthesis
The benzotriazole derivatives as per Scheme 1, were synthesized by conventional and Microwave Irradiation (MWI) methods.
Scheme 1.
Scheme for synthesis of benzotriazole derivatives
Synthesis of 1-(Chloromethyl)-1H-Benzotriazole, 1
Conventional method 16.8 mmol of benzotriazole along with 10 ml DMF was taken in 100 ml RBF, 0.5 ml DCM and 16.8 mmol of Potassium Carbonate was added to it. The reaction was refluxed for 6 h at 80–90 °C followed by pouring into 250 ml beaker containing 25 ml ice cold water. The crystals were filtered and recrystallized with hot water. The synthesized compound was further analysed and characterized.
MWI method 16.8 mmol of benzotriazole along with 10 ml DMF was taken in 100 ml RBF, 0.5 ml DCM and 16.8 mmol of Potassium Carbonate was added to it. The reaction was irradiated at 490 W for 3 min followed by pouring into 250 ml beaker containing 25 ml ice cold water. The crystals were filtered and recrystallized with hot water. The synthesized compound was further analysed and characterized.
FT-IR (KBr υmax cm−1): Ar(=C–H Stretch) 3049 cm−1, Ar(C=C Stretching) 1444.73 cm−1, (C–H bending) 752.26 cm−1, (C–N Ar. amine str) 1261.49 cm−1, (C–Cl halo compound str) 850.64 cm−1. Mass: 167.98, NMR (400 MHz, DMSO-d6,/ppm): 7.6 (d, 1H, Ar.), 7.9 (m, 1H, Ar.), 7.8 (s, 2H, CH2), 8.1 (m, 1H, Ar.).
Synthesis of 1-((1-H-benzo[d][1,2,3]triazol-1-yl)methyl)phenyl hydrazine, 2
Conventional method 0.01 mol of compound 1 along with 0.01 mol Phenyl hydrazine was taken in 100 ml and 12 ml ethanol was added in it. The reaction was refluxed for 2–3 h at 120–130 °C followed by cooling at room temperature. 8 ml of H2SO4 was poured into it with constant stirring for 20–30 min at 30–40 °C. The resultant mixture was cooled at room temperature and poured into 20 ml ice cold water and recrystallized with methanol. The synthesized compound was further analysed and characterized.
MWI method 0.01 mol of compound 1 along with 0.01 mol Phenyl hydrazine was taken in 100 ml and 12 ml ethanol was added in it. The reaction was irradiated at 350 W for 5 min. followed by cooling at room temperature. 8 ml H2SO4 was poured into it with constant stirring for 20–30 min at 30–40 °C. The resultant mixture was cooled at room temperature and poured into 20 ml ice cold water and recrystallized with methanol. The synthesized compound was further analysed and characterized.
FT-IR (KBr υmax cm−1): Ar(=C–H Stretch) 3200.98 cm−1, Ar(C=C Stretching) 1492.95 cm−1, (C–H bending) 754.19 cm−1, (C–N Ar. amine str.) 366.61 cm−1, (N–H str.) 2359.02 cm−1, (N–H bending) 1607.72 cm−1, (C–N Ar. amine str.) 1166.97 cm−1, (NH–NH str.) 3446.91 cm−1. Mass: 239.80, NMR (400 MHz, DMSO-d6,/ppm): 3.6 (s, 1H, NH Ar.), 7.4 (m, 2H, CH2), 7.8–8.0 (m, 9H Ar.), 8.1 (m, 1H, NH).
Synthesis of 1-((1-H-benzo[d][1,2,3]triazol-1-yl)methyl)hydrazine, 3
Conventional method 0.006 mol of compound 1 along with 10 ml DMF was taken in 100 ml RBF. 0.18 mol of Hydrazine and 0.006 mmol of Potassium Carbonate was added in it. The reaction was refluxed for 5 h 30 min at 120–130 °C followed by addition of 10% of HCl to remove excess of Hydrazine and the product was extracted with Chloroform and recrystallized with hot water. The synthesized compound was further analysed and characterized.
MWI method 0.006 mol of Chloromethyl Benzotriazole along with 10 ml DMF was taken in 100 ml RBF. 0.18 mol Hydrazine and 0.006 mmol of Potassium Carbonate was added in it. The reaction was irradiated at 350 W for 3 min followed by addition of 10% of HCl to remove excess of Hydrazine and the product was extracted with Chloroform and recrystallized with hot water. The synthesized compound was further analysed and characterized.
FT-IR (KBr υmax cm−1): Ar(=C–H Stretch) 3001 cm−1, Ar(C=C Stretching) 1448.59 cm−1, (C–H bending) 752.26 cm−1, (C–N Aromatic amine str) 1261.49 cm−1, (N–H str) 2955.04 cm−1, (N–H bending) 850.64 cm−1, Mass: 163.97, NMR (400 MHz, DMSO-d6,/ppm): 8.10 (m, 1H, NH), 7.45 (m, 2H, CH2), 7.65–7.95 (m, 4H Ar.), 3.7 (s, 2H, NH2).
Synthesis of N-(benzo[e] [1, 2, 4] triazin-4(3-H)-ylmethylbenzenamine, 4
Conventional method 0.006 mol of comd. 1 along with 10 ml DMF was taken in 100 ml RBF. 0.18 mol p-toluidine and 0.006 mol of Potassium Carbonate was added in it. The reaction was refluxed for 5 h 30 min at 120–130 °C followed by addition of 10% of HCl to remove excess of p-toluidine and the product was extracted with Chloroform and recrystallized with hot water. The synthesized compound was further analysed and characterized.
MWI method 0.006 mol of Chloromethyl Benzotriazole along with 10 ml DMF was taken in 100 ml RBF in 0.18 mol p-toludine and 0.006 mol of Potassium Carbonate added in to it. The reaction was irradiated at 350 W for 5 min followed by addition of 10% of HCl to remove p-toluidine and the product was extracted with Chloroform and recrystallized with hot water. The synthesized compound was further analysed and characterized.
FT-IR (KBr υmax cm−1): Ar (=C–H Stretch) 2956.01 cm−1, Ar(C=C Stretching) 1493.92 cm−1, (C–H bending) 748.41 cm−1, (C–N Ar. amine str.) 1264.38 cm−1, (N–H str.) 2359.98 cm−1, (N–H bending) 1611.58 cm−1, (C–N Ar amine str.) 1160.22 cm−1,Mass: 238.92, NMR (400 MHz, DMSO-d6,/ppm): 8.10 (m, 1H, NH), 7.45 (m, 2H, CH2), 2.5 (s, 3H, CH3), 7.6–8.0 (m, 8H Ar.).
In Vitro Antimicrobial Studies
The compounds (1–4) were screened against bacterial strains E. coli and B. subtilis; antifungal strains A. niger and C. albicans for concentrations 5, 10 and 15 mg/ml under incubation at 37 °C for 24 h. The antimicrobial activity is displayed by Fig. 2.
Fig. 2.
Antimicrobial activity of compounds (1–4) against a E. coli, b B. subtilis, c Aspergillus niger, d C. albicans
Computational Studies
In silico studies enables researchers to proceed for drug design and development with accurate knowledge of ligand and appropriate binding site of target [22]. Since 1980 onwards, molecular docking has been used as an important tool of computational chemistry in drug discovery [23]. In addition to that useful quantitative data such as binding energy, H- boding, ranking of docked compound etc. are generated through molecular docking algorithms which help a lot for the selection of better lead and target [24]. In present study, compounds (1–4) were taken as ligands and its docking with 4CAW was studied. The docking analytics for ligand and binding sites is displayed through the Fig. 3.
Fig. 3.
Molecular docking of synthesized compounds (1–4) with 4CAW-render protein as cartoon ribbon
Results and Discussion
The comparative yield of synthesized compounds (1–4) through conventional and microwave method is given in Table 1.
Table 1.
Comparative yield analysis of benzotriazole derivatives by conventional and MWI method
| Compound | Mol. formula | Mol. weight (g/mol) | Recrystallization solvent | Conventional method | MWI method | ||||||
|---|---|---|---|---|---|---|---|---|---|---|---|
| Yield (%) | Rf | Melting point (°C) | Time taken (h) | Yield (%) | Rf | Melting point (°C) | Watt, time taken (W, min) | ||||
| 1 | C7H6N3Cl | 167.59 | Hot water | 57.67 | 0.76 | 140 | 6.0 | 67.6 | 0.79 | 135 | 490, 3 |
| 2 | C7H9N5 | 163.17 | Hot water | 82.47 | 0.46 | 122 | 5.30 | 93.81 | 0.48 | 119 | 350, 3 |
| 3 | C14H13N3 | 223.27 | Hot water | 64.66 | 0.85 | 124 | 5.30 | 74.43 | 0.90 | 120 | 350, 5 |
| 4 | C13H13N5 | 239.28 | Methanol | 50.8 | 0.49 | 125 | 3.0 | 79.83 | 0.55 | 123 | 350, 5 |
On analysing the data, it was found that yield for compound 1 was 57.67% under the reflux of 6 h whereas the yield obtained through MWI was 67.6% at 490 W in 3 min. The yield obtained for compound 2 was 82.47% under the reflux of 5 h 30 min whereas through MWI method was 93.81% at 350W in 3 min. The yield obtained for compound 3 was 64.66% under the reflux of 5 h 30 min. whereas through MWI method was 74.43% at 350 W in 5 min. The yield obtained for compound 4 was 50.8% under the reflux of 3 h whereas the yield obtained through microwave irradiation method was 79.83% at 350 W in 5 min. Hence It was reported that the time taken for synthesis of compounds is less along with high yield in case of microwave irradiation method as compare to conventional method.
The data collected after screening for antimicrobial activities is given in Table 2.
Table 2.
Antimicrobial activity of benzotriazole derivatives
| Inhibition zone in (mm) with concentration | ||||||||||||
|---|---|---|---|---|---|---|---|---|---|---|---|---|
| Compound | Escherichia coli | Bacillus subtilis | Aspergillus niger | Candida albicans | ||||||||
| 5 mg/ml | 10 mg/ml | 15 mg/ml | 5 mg/ml | 10 mg/ml | 15 mg/ml | 5 mg/ml | 10 mg/ml | 15 mg/ml | 5 mg/ml | 10 mg/ml | 15 mg/ml | |
| 1 | 8.0 | 10.0 | 11.0 | 5.0 | 6.0 | 8.0 | 6.0 | 8.0 | 10.0 | 4.0 | 6.0 | 8.0 |
| 2 | 5.0 | 7.0 | 8.0 | 5.0 | 7.0 | 8.0 | 4.0 | 6.5 | 7.0 | 5.0 | 8.0 | 9.0 |
| 3 | 4.0 | 6.5 | 8.0 | 4.0 | 6.0 | 7.5 | 5.0 | 6.0 | 10.0 | 6.0 | 8.0 | 9.0 |
| 4 | 9.0 | 11.0 | 12.0 | 8.0 | 9.0 | 10.5 | 8.0 | 13.0 | 16.0 | 2.0 | 5.0 | 6.0 |
The comparative potency of compounds (1–4) against bacterial strains E. coli and B. subtilis; and antifungal strains A. niger and C. albicans is shown in Fig. 4.
Fig. 4.
Comparative antimicrobial activities of synthesized compounds 1–4
Comparative analysis reveals that against E. coli, compound 3 shows lowest potency whereas compound 4 shows highest potency at all concentrations. Against B. subtilis, compound 3 shows lowest potency whereas compound 4 shows highest potency at all concentrations. Against Aspergillus niger, compound 2 shows lowest potency whereas compound 4 shows highest potency at all concentrations. Against C. albicans, compound 4 shows lowest potency whereas compound 3 shows highest potency at all concentrations. Compound 4 takes overall lead.
Molecular docking studies reserves a prestigious position in the computational chemistry which has potential to identify lead compounds that might provide solutions to number of present and future challenges of health care. The computational statistics is given in Table 3,
Table 3.
Molecular docking studies of benzotriazole derivatives with 4CAW
| Compound | Clustering the final poses | Best ligand pose; energy (kcal/mol) | Docking run:elapsed time (s) | Few binding amino acids | H-bonding |
|---|---|---|---|---|---|
| 1 | 36 | − 8.37145 | 9 |
378 SER: beta strand 393 TYR: beta strand 265 HIS: beta strand |
2.868974 2.804591 2.954558 |
| 2 | 76 | − 11.3389 | 9 |
265 HIS: beta strand 393 TYR: beta strand |
2.564498 2.240377 |
| 3 | 58 | − 8.49939 | 8 | 263 TYR: beta strand | 2.893323 |
| 4 | 59 | − 8.50385 | 5 | 265 HIS: beta strand | 2.821388 |
Compound 1 was docked through H-bonding (2.868974, 2.804591 and 2.954558) with amino acids such as 378 SER: beta strand, 393 TYR: beta strand and 265 HIS: beta strand with binding energy − 8.37145 kcal/mol with docking run: elapsed time 9 s. Compound 2 was docked through H-bonding (2.564498, 2.240377) with amino acids such as 265 HIS: beta strand and 393 TYR: beta strand with binding energy − 11.3389 kcal/mol with docking run: elapsed time 9 s. Compound 3 was docked through H-bonding (2.893323) with amino acid 263 TYR: beta strand with binding energy − 8.49939 kcal/mol with docking run: elapsed time 8 s. Compound 4 was found docked through H-bonding (2.821388) with amino acids such as 265 HIS: beta strand with binding energy − 8.50385 kcal/mol with docking run: elapsed time 5 s. The findings of antimicrobial and in silico studies reveals that all of the synthesized benzotriazole derivatives possess promising activity. Compound 4 takes the overall lead.
Conclusions
This study reveals that the time taken for completion of reaction is more and yield is less in conventional methods as compared to microwave irradiation method apart from environmental issues. Moreover, the microwave synthesis is cost effective, time saving and a green approach towards the organic synthesis. 1-((1-H-benzo[d][1,2,3]triazol-1-yl)methyl)phenyl hydrazine shows minimum zone of inhibition against Aspergillus niger. 1-((1-H-benzo[d][1,2,3]triazol-1-yl)methyl)hydrazine shows minimum zone of inhibition against E. coli and B. subtilis, and maximum zone of inhibition against C. albicans. N-(benzo[e][1,2,4] triazin-4(3-H)-ylmethylbenzenamine shows maximum zone of inhibition against E. coli, B. subtilis, A. niger and minimum zone of inhibition against C. albicans. 1-((1-H-benzo[d][1,2,3]triazol-1-yl)methyl)phenyl hydrazine takes lead with best ligand pose energy 11.3389 kcal/mol followed by N-(benzo[e][1,2,4]triazin-4(3-H)-ylmethylbenzenamine (− 8.50385 kcal/mol), 1-((1-H-benzo[d][1,2,3]triazol-1-yl)methyl)hydrazine (− 8.49939 kcal/mol) and 1-(Chloromethyl)-1H-Benzotriazole (− 8.37145 kcal/mol). Thus, all of the synthesized benzotriazole derivatives prove its potential for qualifying as lead compounds in the areas of diverse biological and therapeutic importance. N-(benzo[e][1,2,4]triazin-4(3-H)-ylmethylbenzenamine meets our utmost expectations.
Acknowledgements
The authors are very thankful to the Deans of School of Chemical Engineering and Physical Sciences and School of Bioengineering and Biosciences for providing the research facilities.
Declarations
Conflict of interest
The authors declare no conflict of interest.
Footnotes
Publisher's Note
Springer Nature remains neutral with regard to jurisdictional claims in published maps and institutional affiliations.
References
- 1.AbdElrahman TKAA, Gebreel HMA, Youssef HIA (2023) Assessing the effectiveness of green synthesized zinc oxide nanoparticles in controlling multidrug-resistant clinical bacteria. Indian J Microbiol 63:65–72. 10.1007/s12088-022-01048-3 10.1007/s12088-022-01048-3 [DOI] [PMC free article] [PubMed] [Google Scholar]
- 2.Cantwell MG, Sullivan JC, Burgess RM (2015) Benzotriazoles: history, environmental distribution, and potential ecological effects. Compr Anal Chem 67:513–545. 10.1016/B978-0-444-63299-9.00016-8 10.1016/B978-0-444-63299-9.00016-8 [DOI] [Google Scholar]
- 3.Baran D, Balan A, Stubhan T, Ameri T, Toppare L, Barbec CJ (2012) Photovoltaic properties of benzotrialole containing alternating donar accepter copolymers: effect of alkyl chain length. Synth Met 162:2047–2051. 10.1016/j.synthmet.2012.09.017 10.1016/j.synthmet.2012.09.017 [DOI] [Google Scholar]
- 4.Lei YH, Sheng N, Hyono A, Ueda M (2014) Effect of benzotriazole (BTA) addition on polypyrrole film formation on copper and its corrosion protection. Prog Org Coat 77:339–346. 10.1016/j.porgcoat.2013.10.009 10.1016/j.porgcoat.2013.10.009 [DOI] [Google Scholar]
- 5.Ravichandran R, Nanjundan S, Rajendran N (2005) Corrosion inhibition of brass by benzotriazole derivatives in NaCl solution. Anti-Corros Method 52:226–232. 10.1108/00035590510603265 10.1108/00035590510603265 [DOI] [Google Scholar]
- 6.Shi Z, Liu Y, Xiong Q, Cai W, Ying G (2019) Occurrence, toxicity and transformation of six typical benzotriazoles in the environment: a review. Sci Total Environ 661:407–421. 10.1016/j.scitotenv.2019.01.138 10.1016/j.scitotenv.2019.01.138 [DOI] [PubMed] [Google Scholar]
- 7.Sudhir MS, Nadh RK, Radhika S (2013) Antifungal activities of 1,2,3-benzotriazole derivatives synthesized by ultrasonic and solvent free conditions. Drug Invent 5:126–132. 10.1016/J.DIT.2013.06.004 10.1016/J.DIT.2013.06.004 [DOI] [Google Scholar]
- 8.Rezaei Z, Khabnadideh S, Pakshir K, Hossaini Z, Amiri F, Assadpour E (2009) Design, synthesis, and antifungal activity of triazole and benzotriazole derivatives. Eur J Med Chem 44:3064–3067. 10.1016/j.ejmech.2008.07.012 10.1016/j.ejmech.2008.07.012 [DOI] [PubMed] [Google Scholar]
- 9.Zhang S, Luo Y, He LQ, Liu Z, Jiang A, Yang Y, Zhu H (2013) Synthesis, biological evaluation, and molecular docking studies of novel 1,3,4-oxadiazole derivatives possessing benzotriazole moiety as FAK inhibitors with anticancer activity. Bioorg Med Chem 21:3723–3729. 10.1016/j.bmc.2013.04.043 10.1016/j.bmc.2013.04.043 [DOI] [PubMed] [Google Scholar]
- 10.Swider R, Mastyk A, Zapico JM, Coderch J, Panchuk R, Skorokhyd N, Schnitzler A, Neifind K, Teresa BP, Ramos A (2015) Synthesis, biologiacal activity and structural study of new benzotriazole- based protein kinase CK2 inhibitor. RSC 5:72482–72494. 10.1039/c5ra12114k 10.1039/c5ra12114k [DOI] [Google Scholar]
- 11.Bosque A, Nilson Macedo AB, Spivak AM, Wagoner RM, Martins LJ, Novis CL, Szaniawski MA, Ireland CM, Margolis DM, Price DH, Planelles V (2017) Benzotriazoles reactivate latent HIV-1 through inactivation of STAT5 SUMOylation. Cell Rep 18:1324–1334. 10.1016/j.celrep.2017.01.022 10.1016/j.celrep.2017.01.022 [DOI] [PMC free article] [PubMed] [Google Scholar]
- 12.Feng H, Cao J, Li J, Zhang H, Xue Q, Liu X, Zhang A, Fu J (2020) Estrogenic activity of benzotriazole UV stabilizers evaluated through in vitro assays and computational studies. Sci Total Environ 727:138549. 10.1016/j.scitotenv.2020.138549 10.1016/j.scitotenv.2020.138549 [DOI] [PubMed] [Google Scholar]
- 13.Sudhir MS, Nadh RV (2013) Evaluation of in vitro anthelmintic activities of novel 1,2,3, benzotriazole derivatives synthesized in ultrasonic and solvent free conditions. J Pharm Res 7:47–52. 10.1016/j.jopr.2013.01.004 10.1016/j.jopr.2013.01.004 [DOI] [Google Scholar]
- 14.Singh NP, Kumar R, Prasad DN, Sharma S, Silakari O (2011) Synthesis and antibacterial activity of benzotriazole substituted acridines. Int J Biol Chem 5:193–199. 10.3923/ijbc.2011.193.199 10.3923/ijbc.2011.193.199 [DOI] [Google Scholar]
- 15.Kumar PB, Kini SG, Mubeen M (2014) Synthesis, antimicrobial and docking studies of novel benzotriazole derivatives. Int J Pharma Bio Sci 5:35–42 [Google Scholar]
- 16.Suma BV, Natesh NN, Venkataramana CHS, Jays J, Madhavan V (2012) Synthesis and antibacterial of some new 1,2,3 benzotriazole derivatives containing pyrazolidinedione moieties. Int J Pharm Pharm Sci 4:169–173 [Google Scholar]
- 17.Caliendo G, Carlo RD, Greco G, Meli R, Noveliino E, Peressutti E, Santagada V (1995) Synthesis and biological activity of benzotriazole derivatives structurally related to trazodone. Eur J Med Chem 30:77–84. 10.1016/0223-5234(96)88212-2 10.1016/0223-5234(96)88212-2 [DOI] [Google Scholar]
- 18.Jhamkhandi CM, Disouza JI (2013) Evaluation of antioxidant activity of some benzotriazole substituted with N-phenylacetamide and acetylcarbamic acid derivatives. Int J Pharm Pharm Sci 5:249–253 [Google Scholar]
- 19.Jain NP, Upasani CD, Kalkotwar RS, Jain UN (2013) Synthesis and anti-inflammatory activity of N-(Alkyl or Aryl)-2-(1H benzotriazol-1-yl) acetamide derivatives. RJPBCS 3:1470–1481 [Google Scholar]
- 20.Hameed S, Kanwal Seraj F, Rafique R, Chigurupati S, Wadood A, Rehman AU, Venugopal V, Salar U, Taha M, Khan KM (2019) Synthesis of benzotriazoles derivatives and their dual potential as α-amylase and α-glucosidase inhibitors in vitro: structure-activity relationship, molecular docking, and kinetic studies. Eur J Med Chem 183:111677. 10.1016/j.ejmech.2019.111677 10.1016/j.ejmech.2019.111677 [DOI] [PubMed] [Google Scholar]
- 21.Balouiri M, Sadiki M, Ibnsouda SK (2016) Methods for in vitro evaluating antimicrobial activity: a review. J Pharm Anal 6:71–79. 10.1016/j.jpha.2015.11.005 10.1016/j.jpha.2015.11.005 [DOI] [PMC free article] [PubMed] [Google Scholar]
- 22.Batool M, Ahmad B, Choi SA (2019) Structure-based drug discovery paradigm. Int J Mol Sci 20:2783. 10.3390/ijms20112783 10.3390/ijms20112783 [DOI] [PMC free article] [PubMed] [Google Scholar]
- 23.Castelli M, Serapian SA, Marchetti F, Triveri A, Pirota V, Torielli L, Collina S, Doria F, Freccero M, Colombo G (2021) New perspectives in cancer drug development: computational advances with an eye to design. RSC Med Chem 12:1491–1502. 10.1039/D1MD00192B 10.1039/D1MD00192B [DOI] [PMC free article] [PubMed] [Google Scholar]
- 24.Temml V, Kutil Z (2021) Structure-based molecular modeling in SAR analysis and lead optimization. Comput Struct Biotechnol J 4:1431–1444. 10.1016/j.csbj.2021.02.018 10.1016/j.csbj.2021.02.018 [DOI] [PMC free article] [PubMed] [Google Scholar]